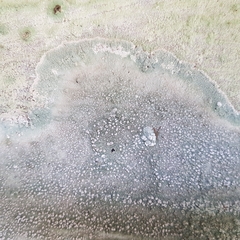
Lecanora subcarnea

Lecanora subcarnea: taxon details and analytics
- Domain
- Kingdom
- Fungi
- Phylum
- Ascomycota
- Class
- Lecanoromycetes
- Order
- Lecanorales
- Family
- Lecanoraceae
- Genus
- Lecanora
- Species
- Lecanora subcarnea
- Scientific Name
- Lecanora subcarnea
Summary description from Wikipedia:
Lecanora subcarnea in languages:
- Finnish
- louhukehräjäkälä
- Russian
- Леканора Светло-телесная
Images from inaturalist.org observations:
We recommend you sign up for this excellent, free service.
Parent Taxon
Sibling Taxa
- Lecanora aberrata
- Lecanora achariana
- Lecanora achroa
- Lecanora achroides
- Lecanora actophila
- Lecanora aitema
- Lecanora alaskensis
- Lecanora alba
- Lecanora albella
- Lecanora albellula
- Lecanora albidorufa
- Lecanora albocaesiella
- Lecanora albospersa
- Lecanora albula
- Lecanora aleutica
- Lecanora allanii
- Lecanora allophana
- Lecanora alpigena
- Lecanora anakeestiicola
- Lecanora andina
- Lecanora annularis
- Lecanora anopta
- Lecanora anoptiza
- Lecanora apochroeoides
- Lecanora appalachensis
- Lecanora arenisaxicola
- Lecanora argentata
- Lecanora argentea
- Lecanora argopholis
- Lecanora atraeformis
- Lecanora atrosulphurea
- Lecanora austrocalifornica
- Lecanora austrointumescens
- Lecanora barkmaniana
- Lecanora bicincta
- Lecanora blanda
- Lecanora bogotana
- Lecanora bolcana
- Lecanora boligera
- Lecanora brandegeei
- Lecanora brattiae
- Lecanora brodoana
- Lecanora bryopsora
- Lecanora cadubriae
- Lecanora caesiopallens
- Lecanora caesiorubella
- Lecanora caesiosora
- Lecanora caesiosulphurea
- Lecanora californica
- Lecanora campestris
- Lecanora canadensis
- Lecanora candidata
- Lecanora caperatica
- Lecanora carneoflava
- Lecanora carneolutescens
- Lecanora carpinea
- Lecanora carpoides
- Lecanora cateilea
- Lecanora cavicola
- Lecanora cenisia
- Lecanora cenisioides
- Lecanora chlarotera
- Lecanora chloroleprosa
- Lecanora chlorophaeodes
- Lecanora chondroderma
- Lecanora cinefacta
- Lecanora cinereofusca
- Lecanora circumborealis
- Lecanora cladonioides
- Lecanora collatolica
- Lecanora comonduensis
- Lecanora compallens
- Lecanora confusa
- Lecanora congesta
- Lecanora coniferarum
- Lecanora conizaeoides
- Lecanora crassa
- Lecanora cruda
- Lecanora cupressi
- Lecanora cyrtospora
- Lecanora darlingiae
- Lecanora dasycarpa
- Lecanora demersa
- Lecanora demosthenesii
- Lecanora densa
- Lecanora discoensis
- Lecanora elapheia
- Lecanora elatinoides
- Lecanora elixii
- Lecanora epanora
- Lecanora epibryon
- Lecanora expallens
- Lecanora exspersa
- Lecanora farinacea
- Lecanora farinaria
- Lecanora fertilissima
- Lecanora fimbriatula
- Lecanora flavidofusca
- Lecanora flavidomarginata
- Lecanora flavidorufa
- Lecanora flavopallescens
- Lecanora flavopallida
- Lecanora flexuosa
- Lecanora floridula
- Lecanora flotoviana
- Lecanora frustulosa
- Lecanora fulva
- Lecanora fulvastra
- Lecanora fuscescens
- Lecanora galactiniza
- Lecanora gangaleoides
- Lecanora geophila
- Lecanora gisleriana
- Lecanora glabrata
- Lecanora granulifera
- Lecanora groenlandica
- Lecanora gypsicola
- Lecanora handelii
- Lecanora haywardiorum
- Lecanora helicopis
- Lecanora helva
- Lecanora horiza
- Lecanora hybocarpa
- Lecanora hypocrocina
- Lecanora hypopta
- Lecanora hypoptoides
- Lecanora impudens
- Lecanora imshaugii
- Lecanora inaurata
- Lecanora insignis
- Lecanora interjecta
- Lecanora intricata
- Lecanora intumescens
- Lecanora iowensis
- Lecanora jamesii
- Lecanora kariana
- Lecanora kohu
- Lecanora labiosa
- Lecanora latens
- Lecanora laxa
- Lecanora layana
- Lecanora lendemeri
- Lecanora leprosa
- Lecanora leptacina
- Lecanora leptacinella
- Lecanora leptyrodes
- Lecanora limosescens
- Lecanora lividolutea
- Lecanora louisianae
- Lecanora lugubris
- Lecanora luteovernalis
- Lecanora margacea
- Lecanora margarodes
- Lecanora marginata
- Lecanora markjohnstonii
- Lecanora masana
- Lecanora maxima
- Lecanora melacarpella
- Lecanora melaena
- Lecanora mellea
- Lecanora meridionalis
- Lecanora microbola
- Lecanora microfusca
- Lecanora miculata
- Lecanora minutella
- Lecanora monticola
- Lecanora mugambii
- Lecanora mughicola
- Lecanora munzii
- Lecanora nashii
- Lecanora neoalbomarginata
- Lecanora neodegelii
- Lecanora nidulans
- Lecanora nordenskioeldii
- Lecanora norvegica
- Lecanora nothocaesiella
- Lecanora novaehollandiae
- Lecanora obvirescens
- Lecanora ochraceorubescens
- Lecanora ochrotropa
- Lecanora orae-frigidae
- Lecanora oreinoides
- Lecanora orizabana
- Lecanora orosthea
- Lecanora ostracoderma
- Lecanora pacifica
- Lecanora paddensis
- Lecanora pallidochlorina
- Lecanora panis-erucae
- Lecanora pannonica
- Lecanora parmelinoides
- Lecanora peninsularis
- Lecanora perflavida
- Lecanora permutata
- Lecanora perplexa
- Lecanora phaeophora
- Lecanora phaeostigma
- Lecanora phryganitis
- Lecanora placidensis
- Lecanora placodiolica
- Lecanora platylepis
- Lecanora plumosa
- Lecanora poliophaea
- Lecanora poluninii
- Lecanora polytropa
- Lecanora polytypa
- Lecanora populicola
- Lecanora praesistens
- Lecanora printzenii
- Lecanora prosecha
- Lecanora proserpens
- Lecanora protervula
- Lecanora pruinosa
- Lecanora psaromela
- Lecanora pseudargentata
- Lecanora pseudistera
- Lecanora pseudodecorata
- Lecanora pseudolivacea
- Lecanora pseudomellea
- Lecanora pseudosarcopidoides
- Lecanora pulchella
- Lecanora pulicaris
- Lecanora pulverulenta
- Lecanora pulvinaris
- Lecanora queenslandica
- Lecanora quercicola
- Lecanora reagens
- Lecanora rehmannii
- Lecanora retracta
- Lecanora reuteri
- Lecanora rhodi
- Lecanora ripartii
- Lecanora rubicunda
- Lecanora rubrocincta
- Lecanora rufocarnea
- Lecanora rupicola
- Lecanora sachsiana
- Lecanora salicicola
- Lecanora saligna
- Lecanora sarcopidoides
- Lecanora saxigena
- Lecanora scanica
- Lecanora scrobiculata
- Lecanora semitensis
- Lecanora septentrionalis
- Lecanora sierrae
- Lecanora silvae-nigrae
- Lecanora simeonensis
- Lecanora sinuosa
- Lecanora sophodopsella
- Lecanora soralifera
- Lecanora sphaerospora
- Lecanora stenotropa
- Lecanora stramineoalbida
- Lecanora strobilina
- Lecanora strobilinoides
- Lecanora subaurea
- Lecanora subcarnea
- Lecanora subcarpinea
- Lecanora subcavicola
- Lecanora subcoarctata
- Lecanora subimmergens
- Lecanora subimmersa
- Lecanora subintricata
- Lecanora sublivescens
- Lecanora subpallens
- Lecanora subravida
- Lecanora subrugosa
- Lecanora subsaligna
- Lecanora substrobilina
- Lecanora substylosa
- Lecanora subsulphurata
- Lecanora subumbrina
- Lecanora sulphurea
- Lecanora swartzii
- Lecanora symmicta
- Lecanora symmictoides
- Lecanora texana
- Lecanora thallina
- Lecanora thallophila
- Lecanora thysanophora
- Lecanora transvaalensis
- Lecanora tristiuscula
- Lecanora tropica
- Lecanora turbinata
- Lecanora umbricolor
- Lecanora umbrosa
- Lecanora utahensis
- Lecanora vacillans
- Lecanora vainioi
- Lecanora valesiaca
- Lecanora varia
- Lecanora vegae
- Lecanora vincentina
- Lecanora viridiatra
- Lecanora viriduloflava
- Lecanora willeyi
- Lecanora wisconsinensis
- Lecanora xanthoplumosella
- Lecanora xanthosora
- Lecanora xanthostoma
- Lecanora xylophila
- Lecanora zeroensis